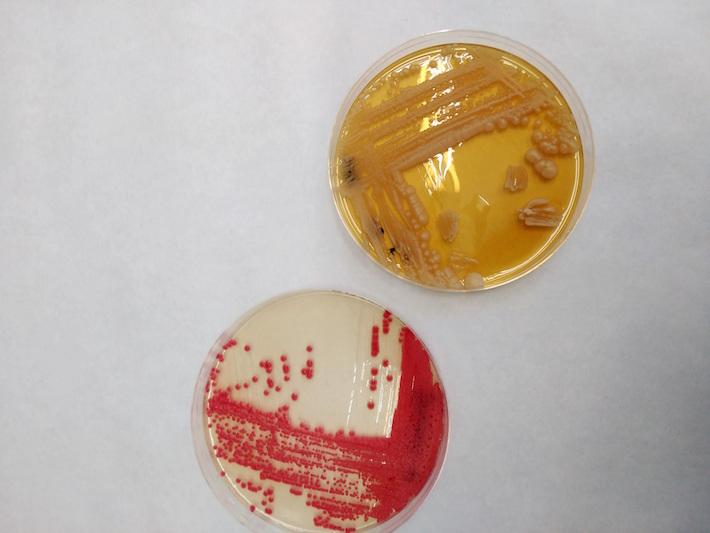

Las ampliaciones de este trabajo podrían estudiar el origen de esta sustancia y su contribución a la salud infantil y en concreto a la inmunidad
Castellón Información
Investigadores del Instituto de Agroquímica y Tecnología de Alimentos (IATA) del Consejo Superior de Investigaciones Científicas (CSIC), de la Fundación para el Fomento de la Investigación Sanitaria y Biomédica de la Comunitat Valenciana (FISABIO) y del grupo de Investigación en Nutrición Pediátrica del Hospital Clínico Universitario de Valencia, han detectado la presencia de levaduras en muestras de leche materna de mujeres sanas. Los resultados del trabajo, que han sido publicados en la revista 'Scientific Reports', amplían los conocimientos sobre la salud infantil.
El desarrollo de la microbiota en el recién nacido es un proceso gradual y crucial, que contribuye a nivel fisiológico y en el desarrollo y maduración del sistema inmunitario. Durante el parto, el recién nacido está expuesto a los microbios maternos, primero del sistema reproductivo de la madre, después de la piel materna y el medio ambiente, y posteriormente influenciado por la dieta, que incluye la lactancia materna. La leche materna juega un papel importante en el suministro microbiano, ya que contiene una variedad de posibles bacterias beneficiosas, así como una amplia fuente de nutrientes y sustancias protectoras esenciales que la convierten en la nutrición óptima para el bebé.
María Carmen Collado, investigadora del CSIC en el IATA, explica que “las bacterias presentes en la leche materna se transmiten al bebé durante la lactancia, llegan al intestino y contribuyen al asentamiento de la microbiota intestinal y la inmunidad adquirida. Aunque las bacterias de la leche humana se han estudiado ampliamente, apenas se dispone de información sobre la presencia natural de especies de levaduras, que se limita a unos pocos estudios. Sin embargo, sí existen estudios acerca de la presencia de levaduras en la leche de otros mamíferos, lo que respalda la idea de que la leche materna humana también pueda contener levaduras en condiciones normales y saludables”.
El trabajo de los investigadores ha consistido en analizar las muestras de leche materna de 41 madres lactantes sanas dentro de un mes después del nacimiento. Mediante técnicas de microscopía, crecimiento de cultivos y secuenciación genética, se confirmó la presencia de levaduras. Además, los macronutrientes de la leche y las células somáticas humanas se cuantificaron a través de técnicas de espectrofotometría y citometría. Los resultados mostraron que el 89 % de las muestras tenían niveles detectables de ADN de levaduras. Utilizando diferentes medios de cultivo, se aislaron e identificaron 33 cepas, lo que confirmó la presencia de especies de levaduras viables. Mediante microscopía fluorescente se comprobó que los géneros más comunes fueron Malassezia (44 %), seguido de Candida (19 %) y Saccharomyces (12 %).
Amparo Querol, investigadora del IATA, experta en levaduras industriales y en seguridad alimentaria, destaca “la importancia del origen de las cepas de S. cerevisiae aisladas en el presente trabajo, ya que forman parte de una población frecuentemente utilizada en la industria, como son las levaduras panaderas. Probablemente el origen de estas levaduras sea similar al de las bacterias presentes en la leche materna, que se podrían transmitir al bebé durante la lactancia. Conocer el origen y el papel en la inmunidad del bebé de estas levaduras es de gran relevancia”.
Alex Mira, investigador de la Fundación FISABIO, recalca que “detectar bacterias y levaduras en muestras humanas se suele asociar a organismos infecciosos; sin embargo, cuando hablamos de microorganismos que ocurren de forma natural en la leche materna, hablamos de microbios inocuos o beneficiosos. El recién nacido necesita estar expuesto a microorganismos para desarrollar su sistema inmune y para otras funciones vitales, las cuales estamos empezando a entender”.
Las futuras ampliaciones de este trabajo podrían estudiar el origen de estas levaduras y su posible contribución a la salud infantil.